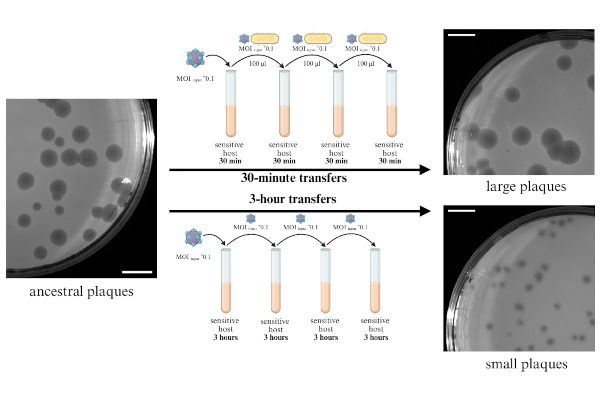

Single capsid mutations modulating phage adsorption, persistence, and plaque morphology shape evolutionary trajectories in ΦX174
Single capsid mutations modulating phage adsorption, persistence, and plaque morphology shape evolutionary trajectories in ΦX174
M Reuter, M Sieber, O Reyes-Matte, C Vasileiou, C Böhmker, J Romeyer Dherbey, F Bertels, J Lopez-Garrido
Virus Evolution, accepted (2026)
 Earlier timing of seasonal respiratory infections and seasonal mortality during the COVID-19 pandemic
Earlier timing of seasonal respiratory infections and seasonal mortality during the COVID-19 pandemic
M Sieber, A Traulsen
medRxiv, preprint (2024)
 Gut-associated functions are favored during microbiome assembly across C. elegans life
Gut-associated functions are favored during microbiome assembly across C. elegans life
J Zimmermann, A Piecyk, M Sieber, C Petersen, J Johnke, L Moitinho-Silva, S Künzel, L Bluhm, A Traulsen, C Kaleta, H Schulenburg
mBio, 15:e00012-24 (2024)
 Suboptimal environmental conditions prolong phage epidemics in bacterial populations
Suboptimal environmental conditions prolong phage epidemics in bacterial populations
H Goehlich, O Roth, M Sieber, CM Chibani, A Poehlein, J Rajkov, H Liesegang, CC Wendling
Molecular Ecology, 33:e17050 (2024)
 The microbiome of the marine flatworm Macrostomum lignano provides fitness advantages and exhibits circadian rhythmicity
The microbiome of the marine flatworm Macrostomum lignano provides fitness advantages and exhibits circadian rhythmicity
Y Ma, J He, M Sieber, J v Frieling, I Bruchhaus, JF Baines, U Bickmeyer, T Roeder
Communications Biology, 6:289 (2023)
 Higher phage virulence accelerates the evolution of host resistance
Higher phage virulence accelerates the evolution of host resistance
CC Wendling, J Lange, H Liesegang, M Sieber, A Poehlein, B Bunk, J Rajkov, H Goehlich, O Roth, MA Brockhurst
Proceedings of the Royal Society B 289:20221070 (2022)
 On the effect of inheritance of microbes in commensal microbiomes
On the effect of inheritance of microbes in commensal microbiomes
R Zapién-Campos, F Bansept, M Sieber, A Traulsen
BMC Ecology and Evolution 22:75 (2022)
 Dynamic proteome allocation regulates the profile of interaction of auxotrophic bacterial consortia
Dynamic proteome allocation regulates the profile of interaction of auxotrophic bacterial consortia
D Reyes-González, H De Luna-Valenciano, J Utrilla, M Sieber, R Peña-Miller, A Fuentes-Hernández
Royal Society Open Science 9:212008 (2022)
 The effect of microbial selection on the occurrence-abundance patterns of microbiomes
The effect of microbial selection on the occurrence-abundance patterns of microbiomes
R Zapién-Campos, M Sieber, A Traulsen
Journal of the Royal Society Interface 19:20210717 (2022)
 Evolutionary ecology theory: Microbial population structure
Evolutionary ecology theory: Microbial population structure
A Traulsen, M Sieber
Current Opinion in Microbiology 63:216-220 (2021)
 Evolution of microbiota-host associations: the microbe's perspective
Evolution of microbiota-host associations: the microbe's perspective
N Obeng, F Bansept, M Sieber, A Traulsen, H Schulenburg
Trends in Microbiology 29:779-787 (2021)
 On the evolutionary origins of host-microbe associations
On the evolutionary origins of host-microbe associations
M Sieber, A Traulsen, H Schulenburg, AE Douglas
PNAS 118:e2016487118 (2021)
 Stochastic colonization of hosts with a finite lifespan can drive individual host microbes out of equilibrium
Stochastic colonization of hosts with a finite lifespan can drive individual host microbes out of equilibrium
R Zapién-Campos, M Sieber, A Traulsen
PLoS Computational Biology 16:e1008392 (2020)
 Bacteriophage can promote the emergence of physiologically sub-optimal host phenotypes
Bacteriophage can promote the emergence of physiologically sub-optimal host phenotypes
H Schenk, M Sieber
bioRxiv, preprint (2019)
 Neutrality in the Metaorganism
Neutrality in the Metaorganism
M Sieber, L Pita, N Weiland-Bräuer, P Dirksen, J Wang, B Mortzfeld, S Franzenburg, RA Schmitz, JF Baines, S Fraune, U Hentschel, H Schulenburg, TCG Bosch, A Traulsen
PLoS Biology 17:e3000298 (2019)
 Functions of the microbiota for the physiology of animal metaorganisms
Functions of the microbiota for the physiology of animal metaorganisms
D Esser, J Lange, G Marinos, M Sieber, L Best, D Prasse, J Bathia, M Rühlemann, K Boersch, C Jaspers, F Sommer
Journal of Innate Immunity 11:393-404 (2019)
 One man's trash is another man's treasure - the effect of bacteria on phytoplankton-zooplankton interactions in chemostat systems
One man's trash is another man's treasure - the effect of bacteria on phytoplankton-zooplankton interactions in chemostat systems
M Raatz, S Schälicke, M Sieber, A Wacker, U Gaedke
Limnology and Oceanography: Methods 16:629-639 (2018)
 Temperate phages as self-replicating weapons in bacterial competition
Temperate phages as self-replicating weapons in bacterial competition
XY Li, T Lachnit, S Fraune, TCG Bosch, A Traulsen, M Sieber
Journal of the Royal Society Interface 14:20170563 (2017)
 Eco-evolutionary dynamics in a coevolving host-virus system
Eco-evolutionary dynamics in a coevolving host-virus system
J Frickel, M Sieber, L Becks
Ecology Letters 19:450-459 (2016)
 Do-or-die life cycles and diverse post-infection resistance mechanisms limit the evolution of parasite host ranges
Do-or-die life cycles and diverse post-infection resistance mechanisms limit the evolution of parasite host ranges
M Sieber, I Gudelj
Ecology Letters 17:491-498 (2014)
 Dispersal network structure and infection mechanism shape diversity in a coevolutionary bacteria-phage system
Dispersal network structure and infection mechanism shape diversity in a coevolutionary bacteria-phage system
M Sieber, M Robb, SE Forde, I Gudelj
The ISME Journal 8:504-514 (2014)
 Disease-induced modification of prey competition in eco-epidemiological models
Disease-induced modification of prey competition in eco-epidemiological models
M Sieber, H Malchow, FM Hilker
Ecological Complexity 18:74-82 (2014)
 The hydra effect in predator-prey models
The hydra effect in predator-prey models
M Sieber, FM Hilker
Journal of Mathematical Biology 64:341-360 (2012)
 Prey, predators, parasites: intraguild predation or simpler community modules in disguise?
Prey, predators, parasites: intraguild predation or simpler community modules in disguise?
M Sieber, FM Hilker
Journal of Animal Ecology 80:414-421 (2011)
 Partial differential equations
Partial differential equations
M Sieber, H Malchow
In Modelling complex ecological dynamics. Jopp, Reuter, Breckling (Eds.), Springer-Verlag (2011)
 Noise can prevent onset of chaos in spatiotemporal population dynamics
Noise can prevent onset of chaos in spatiotemporal population dynamics
SV Petrovskii, A Morozov, H Malchow, M Sieber
European Physical Journal B 78:253-264 (2010)
 Oscillations vs. chaotic waves: Attractor selection in bistable stochastic reaction-diffusion systems
Oscillations vs. chaotic waves: Attractor selection in bistable stochastic reaction-diffusion systems
M Sieber, H Malchow
European Physical Journal Special Topics 187:95-99 (2010)
 Noise-induced suppression of periodic travelling waves in oscillatory reaction-diffusion systems
Noise-induced suppression of periodic travelling waves in oscillatory reaction-diffusion systems
M Sieber, H Malchow, SV Petrovskii
Proceedings of the Royal Society A 466:1903-1917 (2010)
 Constructive effects of environmental noise in an excitable prey-predator plankton system with infected prey
Constructive effects of environmental noise in an excitable prey-predator plankton system with infected prey
M Sieber, H Malchow, L Schimansky-Geier
Ecological Complexity 4:223-233 (2007)